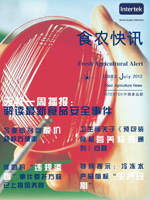
第三十期

《食農快訊》
新一代的《食農快訊》集合了食品以及農產品的一周熱點要聞,讓您能夠更快、更清晰地全面了解食品行業(yè)內的最新動態(tài)與熱點事件,掌握國內外市場的發(fā)展狀況與走勢以及法規(guī)政策的最新發(fā)布情況,通過借鑒最新產品召回案例獲取新的啟示。Intertek始終保持著為客戶提供最好服務的理念。
在《食農快訊》中增添了《天祥一周播報》的欄目,能讓您及時了解到Intertek對每周重大食品安全事件的看法以及相關處理方案,讓您能進一步了解Intertek的服務理念以及實力。Intertek寄望通過《食農快訊》,在Intertek和客戶之間建立起一個全新的互動平臺,拓寬我們增值服務的渠道,不斷為您的產品增加價值。